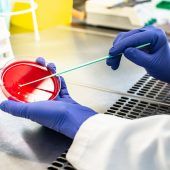

Bregenz startet bei Verfolger Bärnbach in Play-off-Runde.
Vorarlberger Blasmusik- und Chorverband organisieren am Ostersonntag eine Klangwolke mit Ostergruß.

Verbesserung für Pendler aus dem Leibachtal.

Ein neues Ringbiotop schafft ideale Brutmöglichkeiten für gefährdete Wiesenbrüter.

Tanz ist-Festival von Günter Marinelli bereichert jedenfalls schon das Heimkino.

Einfachere Tests zugelassen. Gültigkeit bleibt mit drei Monaten beschränkt.

Nach Wahl in Israel: Kein Block mit nötiger Mehrheit.
Kripo Lindau nahm insgesamt fünf Wohnungen unter die Lupe.

Zugpassagier wollte in S-Bahn den Sicherheitsabstand nicht einhalten.

Wärmere Temperaturen heben zumindest die Stimmung.

Der Gemeinde Raggal fehlen heuer 660.000 Euro.

Sicherungs- und Sanierungsarbeiten am Spielplatz in Göfis abgeschlossen.

Zahlreiche Hotelprojekte und -erweiterungen in der Pipeline.

177 Betriebe im Land mit Ökoprofit-Zertifikat ausgezeichnet.
Blümel an Alleinvorstand: „Schmid AG fertig“.

Ditzer-Truppe verliert zuhause gegen Stockerau 25:26.
Bischofberger sorgte mit dem vierten Tor für die Entscheidung.

Im Doppel scheitert der Feldkircher mit Marcus Daniell an Murray und Soares.

Pforte-Ensemble eröffnet zuversichtlich das Konzertprogramm.

Herzogin will damit dauerhafte Aufzeichnung von Corona-Pandemie erstellen.

Bei der Premiere gab es den 16. und letzten Platz.

Lindau will die Testmöglichkeiten massiv ausbauen.
Noch keine Auswirkungen auf die Intensivstationen.

Bei 2:2 gegen Serbien scheiterte Portugal auch an sich selbst.

Familienverband kreierte zu Ostern eine Überraschung mit Mehrwert.

Klarer 3:0-Heimsieg der Vonach-Truppe gegen Döbling.